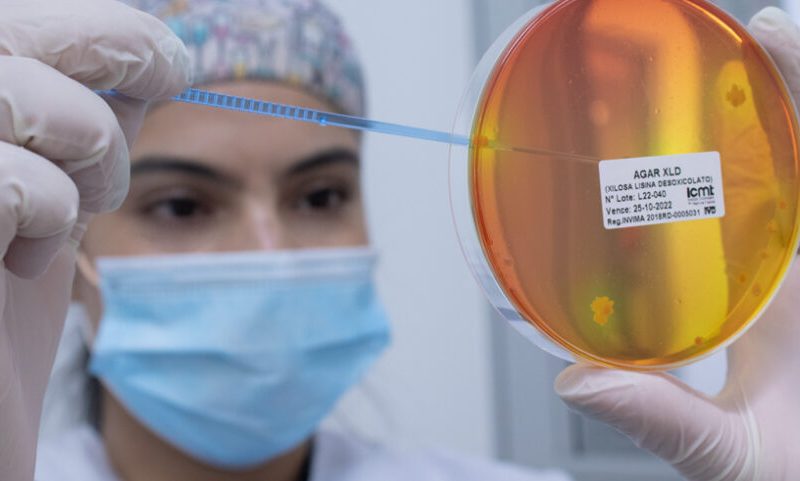

-
Correo
-
Teléfono
(57) 604 3053500 Ext. 2296
-
Sitio web
Instituto Colombiano de Medicina Tropical (ICMT)
Instituto Colombiano de Medicina Tropical investiga para dar solución a las enfermedades tropicales.¿Quiénes somos?
El Instituto Colombiano de Medicina Tropical “Antonio Roldán Betancur” -ICMT-, es una corporación de participación mixta sin ánimo de lucro, con la que buscamos a través de la investigación científica, la docencia, la intervención y consultoría en salud pública, la asistencia en salud humana y animal; y la venta de productos y servicios, solucionar los problemas de la comunidad y de la empresa, ejerciendo una función de liderazgo en el ámbito nacional e internacional, como centro de excelencia en ciencia, tecnología e innovación.
Docencia, servicio y prácticas
Es un centro de investigaciones reconocido por Colciencias en el que rotan estudiantes de diversas carreras y posgrado de la Universidad CES y otras instituciones nacionales e internacionales.
Instalaciones y dotación
- Laboratorio de Investigación: Contamos con infraestructura y dotación necesaria para realizar proyectos de ciencia básica y aplicada, utilizando herramientas para el estudio de agentes infecciosos (parásitos, bacterias, hongos y virus) causantes de enfermedades tropicales en humanos. Para ello, tenemos espacios y herramientas para el aislamiento y cultivo de diferentes tipos de microorganismos y células eucarióticas, herramientas de biología molecular para la obtención y análisis de DNA, RNA y proteínas, herramientas serológicas para la identificación de antígenos o anticuerpos y herramientas de microscopía de luz, campo oscuro y fluorescencia para observación directa de los patógenos.
- IPS ICMT Sabaneta. En la IPS contamos con zona de toma de muestras, un consultorio médico y uno de vacunación habilitados por la Secretaría Seccional de Salud de Antioquia para consulta médica general y especializada, vacunación, diagnóstico y tratamiento enfermedades tropicales, para lo cual ofrecemos un portafolio de pruebas moleculares y serológicas, que nos han convertido en un laboratorio de referencia en enfermedades tropicales al cual son remitidas muestras de pacientes de todo el territorio nacional.
- Laboratorio de Entomología Médica. Es un espacio dotado con equipos y materiales para la identificación y caracterización de vectores de enfermedades tropicales. Allí se encuentra la colección biológica de Entomología Médica, en la que están depositados especímenes de vectores colectados en proyectos de investigación realizados por el ICMT en diferentes regiones del país. De igual manera, se cuenta con una completa colección de garrapatas de interés zoonótico y veterinario, las cuales son material de referencia para investigadores del ICMT y de otras instituciones.
- Laboratorio de Microbiología industrial. Contamos con capacidades para el aislamiento, cultivo, identificación, cuantificación y caracterización de microorganismos en ambientes de trabajo, superficies, operarios, control de calidad de materia prima y producto terminado en la industria cosmética y de alimentos.
- Centros productivos. Ésta área es la responsable de producir insumos y reactivos para diagnóstico in vitro y biológicos para el consumo interno y/o su comercialización en todo el país. Esta área está compuesta por las plantas de producción de reactivos in vitro y la de biológicos.
- Planta de producción de reactivos in vitro. En esta planta contamos con la autorización del INVIMA para la producción y comercialización de 45 referencias de medios de cultivo y colorantes para el diagnóstico microbiológico con registro sanitario del INVIMA. De igual manera, se producen estuches para diagnóstico molecular y recientemente se logró obtener el registro sanitario para el estuche de diagnóstico Inmunotrópica, una herramienta basada en inmunoblots que sirve para la detección de cinco agentes infecciosos (Salmonela sp, Brucela sp, Leptospira sp y parásitos tisulares).
- Planta de producción de biológicos. Es la primera planta para la producción de Biológicos certificada por el INVIMA en Colombia. El ICMT trabaja en la optimización de los procesos para la obtención del registro sanitario de una tuberculina con cepas de Mycobacterium tuberculosis prevalentes en el país, de igual manera se está ampliado la infraestructura para habilitar un espacio para la producción de antivenenos de serpientes.
Nos encontramos ubicados al interior del Hospital Antonio Roldán Betancur en el municipio de Apartadó. Contamos con un edificio independiente propicio para la academia, la ciencia y la prestación de servicios. Además, tenemos tres auditorios para grupos de 20 personas, una sala de cómputo dotada con computadores con acceso a internet, los cuales se utilizan para el desarrollo de programas de especialización y programas de extensión académica de la Universidad CES y de programas de extensión del ICMT ofrecidos a la Alcaldía de Apartadó y otros municipios aledaños.
En la sede de Apartadó contamos con un Laboratorio para investigación y diagnóstico clínico, con énfasis en enfermedades infecciosas, dos consultorios médicos, un consultorio odontológico, y un consultorio para vacunación. Además, tenemos una sala para estudio, una oficina para la coordinación de la sede y una oficina para labores administrativas.
La Secretaría Seccional de Salud de Antioquia nos ha habilitado para prestar los servicios de laboratorio clínico, odontología, pediatría, nutrición, vacunación y enfermedades tropicales. A nuestras instalaciones son remitidos pacientes y muestras para evaluación médica y análisis de laboratorio, provenientes de todos los municipios de la subregión de Urabá y algunos de los Departamentos colindantes (Chocó y Córdoba).
La sede del ICMT en Envigado está ubicada en la Loma del Escobero, dentro de las instalaciones del Centro de Veterinaria y Zootecnia de la Universidad CES. Allí opera el laboratorio veterinario, el cual apoya la investigación básica y aplicada del programa de Medicina Veterinaria y Zootecnia del CES y presta sus servicios de diagnóstico clínico al CVZ y a clínicas veterinarias del Valle de Aburrá, además el laboratorio veterinario abrió una sede en el Municipio de Puerto Berrío en un convenio entre Coregan, la Universidad CES y el ICMT.
Servicios que presta el centro
- Investigación básica y aplicada en enfermedades tropicales, infecciosas y zoonóticas.
- Formación y entrenamiento en diagnóstico y tratamiento de enfermedades tropicales, infecciosas y zoonóticas.
- Diseño, desarrollo, producción y comercialización de reactivos de diagnóstico in vitro y productos biológicos.
- Diagnóstico de enfermedades tropicales e infecciosas.
- Diagnóstico clínico veterinario.
- Análisis de Micriobiología Industrial.
- Consultoría en salud pública y vigilancia epidemiológica.
Sedes
No te pierdas ninguna novedad

Noticias
Conoce los logros, avances y momentos que hacen grande a nuestra comunidad CES.
Explora las noticias
Eventos
Súmate a actividades que inspiran, conectan y transforman cada encuentro en una experiencia.
Explora los eventos
Educación continua
Impulsa tu futuro con cursos y diplomados diseñados para aprender, crecer y especializarte.
Conoce más